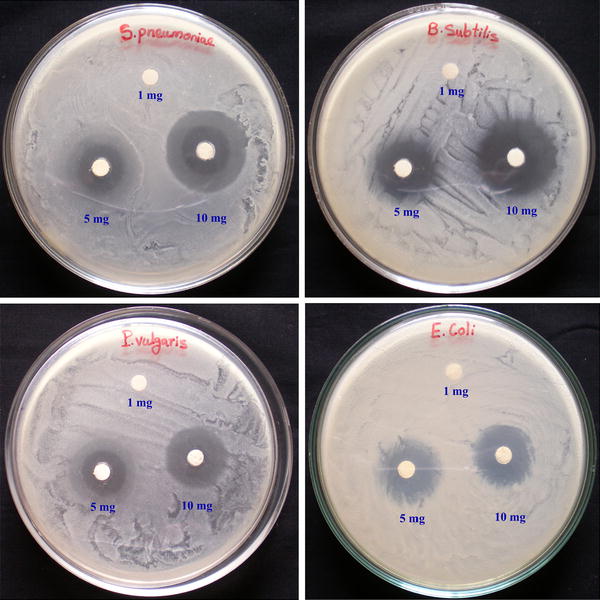

Graphical Abstract

Cerium oxide nanoparticles (CeO 2 NPs) were synthesized using Aspergillus niger culture filtrate. The mycosynthesized CeO 2 NPs were characterized by UV–Visible (UV–Vis), Fourier Transform Infrared (FT-IR), X-ray diffraction (XRD), Micro Raman, Thermogravimetric/Differential Thermal Analysis (TG/DTA), Photoluminescence, and Transmission Electron Microscopy (TEM) analyses. UV–Vis spectrum exhibited a corresponding absorption peak for CeO 2 NPs at 296 nm, and the functional groups present in the fungal filtrate responsible for the synthesis of NPs were analyzed by FT-IR. The further characterization of the mycosynthesized CeO 2 NPs revealed particles of the cubic structure and spherical shape, with the particle sizes ranging from 5 to 20 nm. The antibacterial activity of CeO 2 NPs was examined in respect of two Gram-positive (G+) bacteria ( Streptococcus pneumoniae , Bacillus subtilis ) and two Gram-negative (G−) bacteria ( Proteus vulgaris, Escherichia coli ) by disk diffusion method. The test results for CeO 2 NPs at a concentration of 10 mg/mL showed higher activities on the zone of inhibition of up to 10.67 ± 0.33 and 10.33 ± 0.33 mm against Streptococcus pneumonia and Bacillus subtilis , respectively, The CeO 2 NPs caused 100 % mortality on first instar of Aedes aegypti at 0.250 mg/L concentration after 24-h exposure. The mycosynthesis of CeO 2 NPs is a simple, cost-effective and eco-friendly approach and it will also potentially helpful to control pathogenic bacteria and dengue vector.

Nanotechnology has a variety of applications in our daily life. Nanoparticles possess several physical and chemical properties, due to their high surface-to-volume ratio. Cerium oxide (CeO 2 ) is a semiconductor with a wide band-gap energy (3.19 eV) and a large exciton-binding energy [ 1 ], which is used for a wide range of applications such as electronics [ 2 ], bio-sensors [ 3 ], drug delivery [ 4 ], agriculture [ 5 ], medical field [ 6 ], etc. In general, CeO 2 nanoparticles (CeO 2 NPs) could be synthesized by physical, chemical, and biological (plants and microorganisms) methods [ 7 – 15 ]. Nowadays, biological method offers more advantages such as cost effectiveness, large-scale commercial production, and less time-consuming process [ 16 ].
The fungal extracellular membrane containing metabolites, such as enzymes, proteins, and heterocyclic derivatives, can act as quite promising candidates in the production of reducing and capping agents, with good bio-catalytic performance [ 17 – 20 ]. Over the last two decades, although many researchers focused on transition metal nanoparticles, very few works have been conducted toward the synthesis of metal oxide nanoparticles. In this respect, CeO 2 NPs were synthesized using Humicola sp. culture filtrate [ 21 ]. Moreover, the synthesized nanoparticles are highly stable, water dispersible and exhibit high fluorescent properties and also lack agglomeration, as they are capped naturally by the enzymes secreted from the fungus [ 21 – 23 ].
Aspergillus niger is a filamentous ascomycete fungus and group of saprophytic molds. Generally, A. niger can reproduce by means of conidia. It can grow at 6–47 °C and pH 1.4–9.8. It is an important industrial fungus used for producing citric acid, amylases, lipases, cellulases, xylanases, proteases production, and for removal of heavy metal ions from waste waters [ 24 , 25 ]. Previously, metal nanoparticles were synthesized using A. niger culture filtrate. Fungal filtrate contains enzymes, and anthraquinone compounds are more responsible for reducing and capping processes. The synthesized metal nanoparticles showed better antibacterial and larvicidal activities against bacterial pathogens and mosquito vectors [ 17 , 26 ].
In the present investigation, we propose the synthesis and the characterization of CeO 2 NPs using A. niger culture filtrate and their potential applications for antibacterial and larvicidal activities. The report on the mycosynthesis of CeO 2 NPs describes it as a simple, rapid, water miscible, nontoxic and it provides high yield on a large scale. It can also be used as an alternative biocontrol agent in near future.
Aspergillus niger
culture (Fig.
1
a) was collected from the PG and the Research Department of Plant Biology and Plant Biotechnology, Ramakrishna Mission Vivekananda College, Chennai. The Identified fungus
A. niger
have small size conidia (Fig.
1
b) observed by light microscope (Euromex GE3045, Netherlands) at a magnification of 40X.
a
Aspergillus niger
culture plate,
b
A. niger
conidia,
c
Fungal culture in Czapek-Dox-Broth mediumFig. 1

Fungus, A. niger was inoculated in Czapek-Dox-Broth (CDB) medium, and the flask was incubated at 37 °C, at 120 rpm for 72 h. After the incubation, the produced fungal spores with small white ball-like structure were observed in the medium (Fig. 1 c). The fungal culture medium was filtered using Whatman No.1 filter paper, and the collected fungal filtrate was stored at 4 °C for further use. Thereafter, 3.72 g of CeCl 3 ·7H 2 O was added to 100 mL of fungal filtrate. This solution was stirred constantly at 80 °C for 4–6 h. A white precipitate was formed, and then it became a yellowish brown in color upon continuous stirring in the flask. Further, the precipitate was calcined at 350 and 400 °C for 2 h. Finally, CeO 2 NPs in the form of nanopowders were obtained.
The mycosynthesized CeO 2 NPs were characterized by UV–Vis spectroscopy (Shimadzu, UV-1800) in the wavelengths ranging from 200 to 800 nm continuously operating at a resolution of 1 nm, and FT-IR analysis was carried out in the frequency range of 400–4000 cm −1 . The XRD pattern was recorded using Cu K α radiation ( λ = 1.54060 Å) with nickel monochromator with 2 θ ranging from 10 o to 80 o . The Micro Raman analysis was carried out using 0.5 Focal length triple grating monochromotor excitation source with Ar + laser at 514.5-nm wavelength (Princeton Acton SP2500, CS spectrometer). Thermal behavior of the mycosynthesized CeO 2 NPs was studied by TG/DTA analysis under nitrogen atmosphere (Seiko SSC 5200H), and Photoluminescence measurement was carried out on a luminescence spectrophotometer (Perkin Elmer LS-5513, USA) using xenon lamp as the excitation source at room temperature. The morphology of the CeO 2 NPs was examined using TEM. Samples for TEM analysis were prepared by drop coating the nanoparticle solutions on carbon-coated copper grids at room temperature. The excess nanoparticle’s solution was removed using filter paper. The copper grid was finally dried at room temperature and was subjected to TEM analysis (Tecnai F20) operated at an accelerating voltage of 200 kV.
The antibacterial activity of the mycosynthesized CeO 2 NPs was examined against two Gram-positive (G+) ( Streptococcus pneumoniae , Bacillus subtilis ) and Gram-negative (G−), ( Proteus vulgaris, Escherichia coli ) pathogenic bacteria using disk diffusion method [ 27 ]. The bacterial strains were grown in nutrient broth at 37 °C until the bacterial suspension reached 1.5 × 10 8 CFU/mL. Approximately 20 mL of molten nutrient agar was poured into the Petri dishes and cooled. All the bacterial suspension was swapped over the medium, the disks were loaded at three different concentrations 1, 5, and 10 mg/mL of CeO 2 NPs using sterile distilled water, and then they were placed over the medium using sterile forceps. The plates were then incubated at 37 °C for 24 h. The inhibition zone formed around each disk was measured, and each experiment was conducted in triplicate.
The larvicidal and pupicidal activities of CeO 2 NPs were evaluated, following the method of the World Health Organization (WHO) [ 28 ] with slight modifications. A bio-efficacy test was conducted against developmental stages: I–IV instar and pupa of A. aegypti . Different test concentrations (0.010, 0.050, 0.100, 0.200, and 0.250 mg/L) of CeO 2 NPs and A. niger fungal culture filtrates were prepared in 200 mL deionized water in autoclaved glass bottles of 250-mL capacity. To find the larvicidal and pupicidal activities of CeO 2 NPs and fungal culture filtrate alone, early stages of 20 larvae (I–IV) and pupa were exposed in each test to different concentrations. Similarly, each test included a set of control group (distilled water), and the mortality rate was recorded after 24-h exposure period. Each test was conducted with five replicates.
The percent mortality was observed, and the average mortality data were subjected to Probit analysis for calculating LC 50 and, lower and upper confidence limit values at 95 % using the SPSS software package 9.0 ver. Results with p value of <0.05 were considered to be statistically significant.
Mycosynthesized CeO
2
NPs were subjected to the UV–Vis spectrum analysis in the range from 200 to 800 nm continuously. It exhibited a well-defined absorption peak at 296 nm which indicates that the synthesized CeO
2
NPs have a better optical property (Fig.
2
). The observed peak at 296 nm corresponds to the fluorite cubic structure of CeO
2
NPs due to the quantum size effect of the blue shift in UV–Vis spectrum and confirms the charge between the O 2
p
and Ce 4
f
states in O
2−
and Ce
4+
[
3
,
14
]. The observed result is consistent with the previous report [
29
].
UV–Visible spectrum of the mycosynthesized CeO
2
NPsFig. 2

FT-IR analyses of the fungal culture filtrate, the as-synthesized sample, the calcined samples at 350 and 400 °C were observed (Fig.
3
). FT-IR spectra showed the potential biomolecules responsible for the reduction of CeCl
3
ions for the synthesis of CeO
2
NPs while reacting with
A. niger
culture filtrate. The group of strong, intense bands was observed at 3425, 2360, and 1340 cm
−1
. The intense band at 3425 cm
−1
corresponds to (O–H) mode of hydroxyl molecules. The bands observed at 2360 and 1340 cm
−1
correspond to CeO
2
NPs. These CO
2
bands may arise due to some trapped CO
2
in air ambience. The band at 1642 cm
−1
corresponds to the bending of H–O–H which is partly overlapping the O–C–O stretching band [
30
]. In our case, Ce–O stretching is observed at 468 cm
−1
. The FT-IR spectra for the 400 °C calcined samples showed a band at 3425 cm
−1
of (OH) hydroxyl molecules transmittance percent, which was reduced compared to the spectra of 350 °C calcined samples which is due to the formation of the high crystalline nature of CeO
2
NPs [
3
,
30
].
FTIR-spectra of fungal culture filtrate, as-synthesized sample, and calcined samples at 350 and 400 °CFig. 3

X-ray diffraction patterns were recorded for the as-synthesized and calcined CeO
2
NPs. The as-synthesized and 350 °C calcined samples have not shown any clear, intense peaks, which is due to the amorphous state (Fig.
4
). In addition, the calcined sample at 400 °C exhibited XRD peaks at 28.49°, 33.01°, 47.42°, and 56.28° which can be indexed with (111), (200), (220), and (311) planes, respectively, for the cubic fluorite structure of CeO
2
NPs in the standard data (JCPDS card no: 89-8436). It clearly showed that the peaks become sharper and narrower with the increasing temperature. The low intense peaks at 59.01°, 69.34°, 76.66°, and 79.17° belonged to (222), (400), (331), and (420) planes, respectively [
21
,
31
]. The extra unassigned peaks at 31.51° and 45.25° were observed in the XRD analysis of CeO
2
NPs, which is due to the sulfur oxide impurities [
21
]. The average crystalline size was estimated using the Scherrer formula, and it is estimated to be around 14.95 nm [
20
]. The mycosynthesized CeO
2
NPs was further elucidated by Micro Raman spectroscopy, and it exhibited a strong, intense band at 464 cm
−1
(Fig.
5
). The Raman active mode is attributed to a symmetrical stretching of Ce 8O, which generally corresponds to
F
2g
Raman active mode of fluorite cubic structure [
15
,
32
].
X-ray diffraction patterns of mycosynthesized CeO
2
NPs (
asterisk
shows unassigned peaks) Raman spectrum of the mycosynthesized CeO
2
NPs calcined at 400 °CFig. 4

Fig. 5

Thermogravimetric/differential thermal analysis measurement was performed to examine the thermal stability of the crystalline sample. The TG/DTA curves for the as-synthesized sample recorded in the temperature range from 35 to 1000 °C at a heating rate of 20 °C/min are shown in Fig.
6
. The TGA curves exhibited three stages of decomposition. The first minor weight loss step (9.84 %) from 35 to 100 °C, the second (13.49 %) from 100 to 150 °C, the third (15.25 %) from 150 to 540 °C and also a dramatic weight loss step (15.25 %) were observed from 540 to 1000 °C. The minor weight loss from 35 to 150 °C was related to the losses of water, moisture, and extracellular fungal components. The slight weight losses of fungal organic components were observed with chlorine. Almost no weight loss could be observed above 600 °C [
14
,
30
,
31
]. The two exothermic peaks observed at 115 and 615 °C on the DTA curve represent the strong and minor peaks, respectively, which confirms the combustion of organic residues (115 °C), and decomposition of some residual, absorbed species and oxygen loss at higher temperature (615 °C) [
31
]. Above 740 °C, the gradual increase in DTA curve was ascribed to the phase change or valence variation of cerium [
3
].
TGA/DTA curves of as-synthesized CeO
2
nanopowdersFig. 6

The room temperature PL spectrum of the CeO
2
NPs measured using Xenon laser of 290 nm (Fig.
7
). The spectrum of the CeO
2
NP sample mainly consists of six emission peaks; weak blue bands at 363, 378, 413, and 459 nm; a broad emission band at 395 nm; and a weak blue–green band at 492 nm. The dependence of PL blue-shift peak on CeO
2
NPs concentration has also been observed. This phenomenon has been explained by the charge transition from the 4
f
band to the valance band of the CeO
2
NPs. In this sample, the weak blue and weak blue–green emissions are possibly due to surface defects in the CeO
2
NPs, and the low intensity of the green emission peak due to the low density of oxygen vacancies during the preparation of sample. Broad peaks centered at 395 nm for the CeO
2
sample calcined at 400 °C originate from the defect states existing between the Ce 4
f
state and O 2
p
valence band. The room temperature emission intensity for the CeO
2
sample calcined at 400 °C was attributed to its better crystallinity [
15
].
Photoluminescence spectrum of mycosynthesized CeO
2
NPs calcined at 400 °CFig. 7

The morphology and the structure of the CeO
2
NPs were observed under TEM (Fig.
8
a, b). The images with corresponding selected-area electron diffraction (SAED) patterns and high-resolution TEM images of the CeO
2
NPs were recorded. The mycosynthesized CeO
2
NPs exhibit cubic and spherical morphologies with their sizes ranging from 5 to 20 nm with an average size of about 10 nm. The SAED patterns of CeO
2
NPs show the characteristic ring pattern of fluorite cubic structure, and they confirm the higher degree of crystallinity of CeO
2
NPs (Fig.
8
c) [
30
].
a
,
b
TEM images of mycosynthesized CeO
2
NPs calcined at 400 °C, c selected-area electron diffraction of CeO
2
NPsFig. 8

The antibacterial activity of CeO
2
NPs was performed against two Gram-positive and Gram-negative bacterial human pathogens using three different concentrations of 1, 5, and 10 mg/mL of CeO
2
NPs (Fig.
9
). The CeO
2
NPs of 1 mg/mL concentration did not show any inhibitory effect of zone formation in all tested strains. Then, CeO
2
NPs of 5 mg/mL concentration showed a modulated effect of inhibition zones at
Proteus vulgaris
in 3.67 ± 0.33 mm,
Escherichia coli
in 3.33 ± 0.33 mm,
Streptococcus pneumonia
in 3.33 ± 0.33 mm, and
Bacillus subtilis
in 4.67 ± 0.33 mm. The inhibition zones with significant effect shown by the CeO
2
NPs of 10 mg/mL concentration of are
Streptococcus pneumonia
in 10.67 ± 0.33 mm,
Bacillus subtilis
in 10.33 ± 0.33 mm,
Proteus vulgaris
in 8.33 ± 0.33 mm, and
Escherichia coli
in 6.33 ± 0.33 mm (Fig.
10
). However, the CeO
2
NPs of 10 mg/mL concentration showed higher impact of antibacterial activity in Gram-positive bacteria compared to Gram-negative bacteria. This is because the Gram-positive bacterial cell wall contains a thick layer of peptidoglycan, which is attached to teichoic acids, and this may be the reason for the interaction with CeO
2
NPs in antibacterial activity. The zone of inhibition effect of antibacterial activity depends upon the concentration of CeO
2
NPs. The observed results could be attributed to a binding of metal and metal oxide nanoparticles on to the bacterial cell wall due to the electrostatic attraction between the negatively charged bacteria and the positively charged nanoparticles. This interaction not only inhibits the bacterial growth, but it also induces the generation of the reactive oxygen species (ROS), which leads to cell death [
33
]. The actual mechanism of antibacterial activity of CeO
2
NPs could be an interference with the bacteria cell membrane and binding with mesosome, which thus disturbs the mesosomal functions of cellular respiration, DNA replication, cell division, and increases the surface area of bacterial cell membrane; these intracellular functional changes of oxidative stress are induced by ROS generation due to cell death. The results observed forthe CeO
2
NPs of 10 mg/mL concentration showed the most significant effect of antibacterial activity against the tested Gram-positive and -negative bacteria due to the strong electrostatic forces required to bind the bacterial cell membrane to cause the inhibition of bacterial growth. On the contrary, CeO
2
NPs did not show any antibacterial activity in previous reports, at 10 µg and 10 mg concentrations [
29
,
34
].
Zones of inhibition in CeO
2
NPs at different concentrations against Gram-positive and Gram-negative bacteria Antibacterial activities of CeO
2
NPs against Gram-positive and Gram-negative bacteriaFig.9
Fig. 10

Larvicidal and pupicidal activities of CeO
2
NPs and
A. niger
fungus filtrate were observed against I–IV instar and pupa of
A. aegypti
at five different concentrations (Table
1
). The high mortality rates ranked in descending order against first (100 %), second (92 %), third (76 %), fourth (70 %), and pupa (70 %) were observed at 0.250 mg/L concentration after 24-h exposure period, and their LC
50
values were 0.033, 0.045, 0.074, 0.085, and 0.116 %, respectively. The
A. niger
fungus filtrate showed very low mortality rates of 46, 40, 32, and 28 for I–IV instar and 20 % for pupa, respectively, after 24-h exposure period, and their LC
50
values were calculated as 0.297, 0.353, 0.426, and 0.453, and 0.467 %, respectively, and no mortality was observed in control. Similar kinds of mortality were observed when exposed to Ag NPs produced from
Cochliobolus lunatu
[
35
], and interestingly, 100 % mortality was recorded in early second instar after 1-h exposure of Ag NPs synthesized using
Chrysosporium tropicum
[
17
]. The CeO
2
NPs **showed 2–3-fold higher mortality rate compared to
A. niger
fungus filtrate treatment alone. The exact mechanism is not known clearly till now, even though the obtained results suggest that the CeO
2
NPs could be interrupting the membrane permeability and thus leading to cell death. Recently, it was reported that the penetration of NPs when treated with laveral membrane results in the death of larvae due to interaction with cell molecules [
28
]. In addition, once NPs reach their midgut epithelial membrane, the enzymes become inactivated, and generate peroxide leading to cell death [
36
,
37
].
Anti-developmental activity of CeO
2
NPs produced using
A. niger
extract against
A. aegypti Test substance Instar stages Percent mortality (%) ± SE LC50 95 % Confidence Limit 0.010 mg/L 0.050 mg/L 0.100 mg/L 0.200 mg/L 0.250 mg/L LCL UCL I 12 ± 1.294 18 ± 0.946 22 ± 1.294 30 ± 1.189 46 ± 1.337 0.297 0.248 0.389 1.831 II 10 ± 0.000 18 ± 1.294 20 ± 1.189 24 ± 1.337 40 ± 0.000 0.353 0.284 0.506 3.482 III 10 ± 1.189 12 ± 1.480 16 ± 2.093 20 ± 1.189 32 ± 1.615 0.426 0.329 0.682 1.320 IV 8 ± 0.946 10 ± 1.189 14 ± 1.047 18 ± 1.189 28 ± 2.317 0.453 0.347 0.742 0.859 Pupae 2 ± 0.946 6 ± 1.337 12 ± 0.946 14 ± 2.502 20 ± 1.189 0.467 0.363 0.738 3.311 CeO2 NPs I 46 ± 1.337 52 ± 1.813 72 ± 1.961 88 ± 1.615 100 ± 0.000 0.033 0.041 0.071 7.016 II 42 ± 1.615 48 ± 1.615 68 ± 1.615 80 ± 1.778 92 ± 0.946 0.045 0.017 0.065 2.605 III 38 ± 2.082 42 ± 0.946 60 ± 0.000 72 ± 0.946 76 ± 1.047 0.074 0.412 0.100 2.102 IV 38 ± 0.946 42 ± 0.946 56 ± 1.742 70 ± 1.414 70 ± 0.000 0.085 0.047 0.114 1.929 Pupae 32 ± 1.480 38 ± 1.480 52 ± 0.946 62 ± 0.946 70 ± 0.000 0.116 0.086 0.145 1.111Table 1
CeO 2 NPs have been successfully synthesized using A. niger culture filtrate. The detailed characterization study revealed the formation of CeO 2 NPs cubic fluorite structure and a spherical morphology with the average size of 5 nm. Mycosynthesized CeO 2 NPs showed their potent antibacterial and larvicidal activities against pathogenic bacteria and dengue vector. The mycosynthesis of CeO 2 NPs is a simple, reliable, cost effective and eco-friendly approach, and it can also be extended to synthesize other metal oxide NPs.
The authors gratefully thank the School of Physics, Alagappa University, Karaikudi, for extending the XRD facility.
The Author(s) declare that they have no conflict of interest.
KG, VK, CS, and SG completed the nanoparticles synthesis, characterization, and applications. AA carried out the manuscript preparation. All authors read and approved the final manuscript.